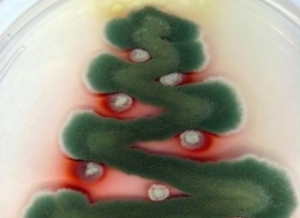

小菌菌过圣诞
发布日期:2019-12-25圣诞节就要来了!你以为这个节日只属于人类吗?细菌和真菌无处不在,它们与人类生活了这么久,也想庆祝圣诞。别看它们是非常小的微生物,但却有着强大的创造力,来看看小菌菌们是怎么准备的。
圣诞快乐!MERRY XMAS!
在西方,每当圣诞节到来之际,人们会彼此道一句“MERRY XMAS!”(英文MERRY XMAS是“Merry Christmas”的缩写版,即“圣诞快乐”的意思)。细菌也想送出自己的祝福,于是,在英国华威大学一名助理教授的帮助下,细菌们突发奇想,用一种特殊的方式祝福大家圣诞快乐。来看看这张图片吧!

(图片来源:phys.org)
M-E-R-R-Y-X-M-A-S!瞧瞧这几个大字,多么有创意的祝福啊,想必圣诞老人见了,也会会心一笑。可是,这究竟是什么东西?
用来做字母的微生物叫做枯草杆菌,这是一种不会让你生病的细菌,广泛存在于土壤以及人体肠道里。
通常,细菌被认为是孤独的单细胞生物,但实际上,细菌是具有社会性的。它们能团结起来,形成具有结构的群落——生物膜。这几个字的制作过程是这样的:首先,让枯草杆菌在30℃的环境中生长14个小时;然后,教授利用印章在培养基中形成字母区域,让生物膜能以字母的形状继续生长;再等待约12个小时,你就能得到写着圣诞快乐的菌菌了。
对于每个单独的细菌来说,生物膜的意义非同凡响,个体命运与集体命运紧密相连。在生物膜内,细菌会分工,并分化为具有不同功能的“角色”,共同维持菌落的生存。
菌菌圣诞树
对于圣诞节来说,圣诞树必不可少!菌菌们也不甘示弱,画了一棵圣诞树。不过这棵圣诞树有点小,是在培养皿上完成的……

这棵栩栩如生的圣诞树,其实是由几种颜色不同的真菌组成的。
我们知道,真菌能够形成群落。而且,真菌群落的颜色十分丰富,有绿色、黑色、褐色、黄色等等,就像你们的水彩笔,正是作画的好选择!
树顶的黄色小星星(柄蓝状菌)、棕色的树干(土曲霉)、白色的铃铛(马尔尼菲青霉菌)、绿色的树枝(构巢曲霉)……不过,要想完成这棵菌菌圣诞树,需要大约12周的培育时间。
那么,为什么真菌群落会有这么多颜色呢?要知道,菌落表面的颜色主要取决于孢子的颜色,如肉眼可见青霉孢子的颜色为蓝绿色;黑曲霉的孢子是黑色的。孢子是什么?孢子是真菌的生殖细胞,孢子在适宜条件下发芽,形成菌丝而进行分裂繁殖;当外界环境不适宜时,孢子可以呈休眠状态,因此能够生存很长时间。
另外,一些真菌也会因为细胞壁含有各种物质,而呈现出不同的颜色。
用同样的方式,菌菌们还“画”了雪人、礼盒、圣诞帽、麋鹿等等,可以说,圣诞的气氛十分浓厚。
怎么样?小菌菌们是不是又聪明又可爱,它们已经准为圣诞节做足了准备。你呢?你准备怎么过圣诞呢?
作者:董依明
审稿:魏潇,中科院心理所博士后研究员、中山大学神经生物学博士

京公网安备11010502039775号
京公网安备11010502039775号





